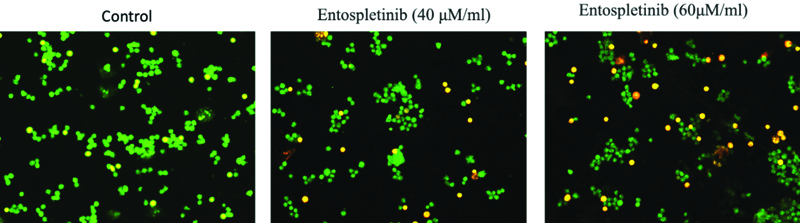

The RB is the most common ocular malignancy in childhood, affects approximately 1 in 16,000 to 28,000 live births annually, constituting roughly 3% of all paediatric malignancies. It is a potentially curable tumour with survival rates as high as 90% in developed countries when identified in its incipient stages [1]. However, survival rates in low to middle-income nations are restricted to 40-60%, primarily due to financial constraints and inadequate diagnostic resources, posing significant challenges. Regrettably, the global distribution shows that the majority of affected children reside in low to middle-income countries, with India shouldering the largest share [2].
While most cases of RB are spontaneous in nature, roughly 40% of patients are predisposed to the disease due to germline mutations in the RB1 gene. The inactivation of RB1 gene allows retinoblasts to acquire unlimited replicative capacity and serves as a crucial limiting factor in the development of RB [3].
Significant advancements in RB treatment have emerged over the past decade, with Intra-arterial Chemotherapy (IAC) emerging as the predominant primary treatment method for intraocular RB. However, IAC is not devoid of certain drawbacks and constraints, one such principal challenge is the potential for vascular complications, like embolism or arterial spasm, which may occur during the procedure. Additionally, the risk of ocular toxicity from the concentrated chemotherapeutic agents poses a threat, potentially leading to vision impairment or other adverse effects. These issues underscore the pressing need for the development of novel therapeutic agents that offer heightened effectiveness while mitigating potential toxicity [4,5].
The epigenetic analysis of human RB revealed substantial differences compared to normal retinoblasts, with one of the most notable findings being the upregulated expression of the proto-oncogene SYK, highlighting it as a key area of interest [6].
SYK is a non-receptor tyrosine kinase that is essential for immune cell signaling, notably B-Cell Receptor (BCR) signaling and immune cell activation [7]. In addition to its proven role in immune function, SYK is also implicated in several facets of cancer genesis and progression, making it a promising therapeutic target in oncology [8]. In the context of RB, SYK has been established as a proto-oncogene essential for cell survival. However, its underlying mechanisms remain inadequately explored. Furthermore, the absence of SYK in normal retinal tissues suggests that SYK inhibitors may have a selective cytotoxic effect on tumour cells while sparing normal ocular tissues [6].
Materials and Methods
This is an in-vitro anti-cancer study on the Y-79 RB cell line. The study was carried out at the central research facility of SRIHER, Chennai, Tamil Nadu, India, between July and December 2023.
Cell line maintenance: Human RB cell lines (Y-79) were supplied by the National Centre for Cell Science (NCCS) in Pune, while human gingival fibroblast cells were sourced from the Central Research Facility at SRIHER. Both cell types were maintained at 37°C in a humidified incubator with 5% CO2, in T25 culture flasks containing 10% Foetal Bovine Serum (FBS), 1% antibiotics, and Modified Eagle’s Medium with Dulbecco (DMEM).
Cell viability (MTT) assay: RB cells were seeded in 96-well plates at 5x103 cells/well. After 24 hours, cells were washed with serum-free medium and starved for three hours at 37°C. Post-starvation, cells were treated with various concentrations of Entospletinib (10-100 μM/mL) for 24 hours. Following treatment, the medium was replaced with MTT-containing DMEM (0.5 mg/mL), and cells were incubated for four hours at 37°C. The MTT medium was removed, cells were washed with PBS, and formazan crystals were dissolved in 100 μl of DMSO and incubated in the dark for one hour. Absorbance at 570 nm was measured using a Micro ELISA reader. Cell viability, expressed as a percentage of the untreated control, was calculated using the formula: % cell viability = {A570 of treated cells/A570 of control cells} ×100.
Morphology study: From the MTT assay, the optimal doses of Entospletinib (IC50: 61.3 μM/mL for RB cell line) for further studies were determined. Morphological changes were assessed using phase-contrast microscopy. For this, 2×105 cells were seeded in 6-well plates and treated with Entospletinib for 24 hours. Following incubation, the medium was discarded, and the cells were rinsed with phosphate-buffered saline (PBS, pH 7.4) before being examined under a phase-contrast microscope.
Acridine Orange (AO)/Ethidium Bromide (EtBr) dual staining: The impact of Entospletinib on RB cell death was evaluated using Acridine Orange (AO) and Ethidium Bromide (EtBr) dual staining. Following 24-hour treatment with Entospletinib, cells were harvested, washed with ice-cold PBS, and resuspended in a mixture of 5 μL of AO (1 mg/mL) and 5μl of EtBr (1 mg/mL). Apoptotic changes in the stained cells were then analysed using a fluorescence microscope.
Apoptosis assay using Annexin-V flow cytometry analysis: The human RB cells were seeded in a 60-mm dish. The cells were treated with and without Entospletinib for 24 hours’ time point. Cell apoptotic death was assessed with an Annexin V/FITC Apoptosis Detection kit (BD Biosciences, Franklin Lakes, NJ, USA). The Entospletinib treated Y-79 cells were harvested and stained with PI and annexin V-FITC, and were measured using a FACS caliber flow cytometer (BD Biosciences).
Real-Time PCR: For the analysis of gene expression of SYK and apoptosis signaling molecules real-time PCR was employed. Isolation of the total RNA was carried out in accordance to the standardised protocol using Trizol Reagent (Sigma). cDNA synthesis was done using a PrimeScript, 1st strand cDNA synthesis kit (TakaRa, Japan). Specific primers were used to amplify the target genesand GoTaq® qPCR Master Mix (Promega) containing SYBR green dye and all necessary components, was used to conduct the real-time PCR reactions in CFX96 PCR system (Biorad). For the analysis of the results comparative cycle threshold (Ct) method was used and fold changes were calculated with the 2-Δ ΔCT method as described by Schmittgen and Livak.
Western blot analysis: Protein levels of NF-κB p65 in Entospletinib-treated RB cells (Y-79) were analysed by Western blot. Post-treatment, cells were washed with ice-cold PBS, lysed with Radio-Immunoprecipitation Assay (RIPA) buffer containing protease inhibitors, and protein concentrations were quantified using the Bradford assay. Protein samples (20-50 μg) were separated by 10% SDS-PAGE and transferred to PVDF membranes via wet transfer. Membranes were incubated overnight with NF-κB p65 (1:1000) and β-actin (1:5000) antibodies at 4°C, followed by a 2-hour incubation with horseradish peroxidase-conjugated secondary antibody (1:10000) at room temperature. Protein bands were visualised using the Bio-Rad (USA) ChemiDoc Imaging System with an Enhanced Chemiluminescence (ECL) detection system.
Statistical Analysis
All experiments were done in triplicate and the data was analysed using GraphPad Prism (version 8). After computation, the data were shown as mean±Standard Deviation (SD). To find variations between the groups, analysis of variance (ANOVA) was performed among the groups, and then the student’s t-test was used. After calculating significance levels, values were deemed significant if p <0.05.
Results
Impact of Entospletinib on the viability and cell morphological changes in Retinoblastoma (RB) cell line.
The MTT assay results revealed a significant reduction in cell proliferation, with percentages of 88.84, 80.32%, 65.78%, 48.70%, 42.28 and 36.80% (p <0.05) in 24 h time points at concentrations of 10, 20, 40, 60, 80 and 100 μM/mL of Entospletinib, respectively in Y-79 cells [Table/Fig-1]. Entospletinib significantly reduced the viability of RB cells compared to the untreated group at both 24-hour time points. The percentage of cell viability gradually decreased with an increase in the concentration of Entospletinib, reaching 50% growth inhibition at a dose of cell viability progressively declined with increasing concentrations of Entospletinib, resulting in 50% growth inhibition at a concentration of 61.3 μM/mL [Table/Fig-1]. Therefore, the aforementioned dose was chosen for subsequent experiments inverted microscopy analysis showed that the treated cells exhibited notable morphological alterations compared to the control cells, including cell shrinkage and reduced cell density, indicative of apoptosis [Table/Fig-2].
Cytotoxicity effects of Entospletinib on Retinoblastoma (RB) cells (Y-79). Cells were exposed to Entospletinib at concentrations ranging from 10 to 100 μM/mL for 24 hours, and cell viability was assessed using the MTT assay. Results are presented as means±SD (n=3). Statistical significance was determined by comparing with the control group (human gingival fibroblast cells), with *indicating p<0.05.

The impact of Entospletinib on the morphology of human Retinoblastoma (RB) cells (Y-79). Cells were treated with Entospletinib at concentrations of 10 to 100 μM/mL for 24 hours and subsequently observed using an inverted phase contrast microscope. Following treatment, a reduction in cell count was noted, along with signs of cell shrinkage and cytoplasmic membrane blebbing.

Entospletinib induces apoptosis by activating the p53-mediated intrinsic apoptotic pathway.
To ascertain whether cultured RB cells undergo apoptosis, we analysed untreated and Entospletinib-treated Y-79 cells using Annexin-V and PI and AO/EtBr dual staining. Entospletinib-treated Y-79 cells exhibited a higher percentage of apoptosis cells when compared to the untreated group. Overall, the percentage of apoptotic cells increased in Entospletinib-treated Y-79 cells (15.48% in 40 and 57.97% in 60 μM/mL, n=3, P≤0.05, [Table/Fig-3] compared to untreated cells, without showing necrotic signs in both Entospletinib treated and control cells. To further understand cell death mechanisms, specifically apoptosis or necrosis, the authors utilised the AO/EtBr dual staining procedure to examine the nuclei morphology in both control and Entospletinib treated cells [Table/Fig-4]. The AO/EtBr dual staining results aligned with our quantitative apoptosis analysis, confirming that the highest rate of apoptosis, characterised by nuclear deformation and loss of cell wall integrity, was observed in RB cells treated with Entospletinib.
To assess the impact of Entospletinib on the intracellular signaling molecules governing its proapoptotic activity in Y-79 cells: As a subsequent analysis, we interrogated the mRNA expression profile of The Bcl-2 protein family, caspase 3 and p53 through real-time PCR. The Bcl-2 protein family includes both pro-apoptotic proteins like Bax and anti-apoptotic proteins like Bcl-2. Activation of this family leads to the release of pro-apoptotic factors, such as cytochrome c, into the cytosol, subsequently initiating caspase activation. p53, on the other hand, is a tumour suppressor gene, and studies suggest that p53 pathway is inactivated in RB Entospletinib demonstrated a substantial rise in the expression of pro-apoptotic proteins, namely Bax, and Caspase-3 and tumour suppressor gene in RB cell lines [Table/Fig-5]. Furthermore, in the Y-79 cell line, it downregulated the expression of the anti-apoptotic protein Bcl-2.
The effect of Entospletinib on apoptosis in Y-79 cancer cells was assessed using annexin V-5-Fluorescein Isothiocyanate (FITC)/Propidium Iodide (PI) staining, followed by flow cytometry. Representative plots illustrate annexin V-FITC/PI staining of Y-79 cells treated with Entospletinib at concentrations of 40 and 60 μM/mL. The graph presents the results from three independent experiments, with data expressed as mean±SD.

Human Retinoblastoma (RB) cells were exposed to Entospletinib at concentrations of 40 and 60 μM/mL for 24 hours, with a control group included for comparison. Following treatment, the cells were stained using Acridine Orange/Ethidium Bromide (AO/EtBr) dual staining and examined using an inverted fluorescence phase contrast microscope to capture the images.
Impact of Entospletinib (60 μM/mL) on the Expression of p53, Bax, BCL-2, and Caspase-3 in Retinoblastoma (RB) Cells. Gene expression levels are normalised to GAPDH mRNA and reported as fold changes relative to the control. Each bar displays the mean±SEM from three independent experiments. Asterisks (*) indicate statistical significance between the control and drug treatment groups, with significance determined at a p <0.05 level.

Entospletinib induces apoptosis of Retinoblastoma (RB) cells by inhibiting the SYK/TNF-a/NFκB signaling pathway.
Further, the authors also explored how Entospletinib influences the mRNA expression levels of key components within the SYK signaling pathway in RB cells. Treatment with Entospletinib (60 μM/mL) resulted in a significant decrease in SYK mRNA expression, a critical component of the signaling pathway implicated in RB cell survival and proliferation compared to untreated control cells. Entospletinib treatment also led to a pronounced reduction in TNF-α mRNA levels in RB cells (p-value<0.05) [Table/Fig-6]. TNF-α is known to activate the NF-κB pathway, promoting cell survival and inflammation. Consistent with the inhibition of TNF-α expression, Entospletinib treatment also resulted in the downregulation of NFκB mRNA [Table/Fig-6] and its protein levels (p-value<0.05) [Table/Fig-7] in RB cells.
Effect of Entospletinib (60 μM/mL) on SYK/TNF-a and NFκB expression in the Retinoblastoma (RB) cell line. Target gene expression levels were normalized to GAPDH mRNA and reported as fold changes relative to the control. Each bar displays the mean±SEM from three independent experiments. Asterisks (*) denote statistical significance between the control and drug treatment groups at a p <0.05 level.

The protein expression of NF-κB p65 in Entospletinib treated Retinoblastoma (RB) cells (Y-79) by western blotting analysis. The protein expression of NF-κB p65 in Entospletinib (40 and 60 μM/mL for 24h) treated Y-79 Retinoblastoma (RB) cellsβ-actin served as the internal control. The data are presented as the mean±SEM from three independent experiments. Asterisks (*) indicate statistical significance between the control and Entospletinib treatment groups, with significance determined at a p <0.05 level using a t-test.

Discussion
The findings of this research offer new perspectives on the intricate molecular pathways involved in the pro-apoptotic effects of Entospletinib on Rb cells and highlight the crucial role of SYK/TNF-α/NFκB signaling in mediating these effects.
As a non-receptor tyrosine kinase, SYK exhibits a range of biological functions in various cell types and have a significant role in haematologic malignancies. In various B cell lymphomas, it is a major facilitator of tonic and chronic signaling through the BCR, promoting cell survival [10,11]. Less is known about SYK’s function in solid tumours, while research on gastric, breast, and melanoma carcinomas supports its tumour-suppressive potential. However, SYK inhibition decreases invasion and cell migration and modifies the immunological makeup of gliomas in syngeneic mice. Human gliomas, on the other hand, display a SYK signaling network linked to tumour growth [12,13].
The authors investigated the impact of the SYK inhibitor Entospletinib on RB cell lines and found that it induces p53-mediated apoptosis. p53 is one of the widely researched tumour suppressor gene in human cancers and p53 pathway inactivation is believed to significantly contribute to the development of RB [14]. p53 plays a central role in managing cellular responses to various stressors by controlling apoptosis, cell cycle arrest, DNA repair, and genetic stability. in the intrinsic apoptosis pathway, p53 interacts with multidomain members of the Bcl-2 family to induce mitochondrial outer membrane permeabilisation [15]. This also entails adjusting the ratio of pro-to anti-apoptotic (Bcl-2) and pro-apoptotic (Bax and Caspase-3) proteins within the Bcl-2 family.
In the current study, it was observed that cells treated with Entospletinib exhibited p53 overexpression, accompanied by higher mRNA expression of pro-apoptotic proteins Bax and Caspase-3, and lower gene expression of the anti-apoptotic protein BCL-2. This implies that p53 plays a crucial role as a mediator of apoptosis in RB. Additionally, the authors discovered that in RB cells, entospletinib suppresses the SYK/ TNF-α/NFκB signaling pathway [16]. SYK is known to control the synthesis of TNF-α, which in turn triggers NFκB signaling and encourages cell survival and proliferation. According to the present findings, entospletinib interferes with this signaling cascade, which inhibits NFκB activation and leads to TNF-α-downregulation and impeding tumour proliferation [17]. This study’s findings could have an impact on how RB is treated in the future. Entospletinib is a potentially effective cancer treatment because it can induce apoptosis via a variety of molecular pathways.
Limitation(s)
Subsequent investigations ought to concentrate on clarifying the molecular pathways that underlie Entospletinib’s apoptotic actions and assessing its effectiveness in preclinical and clinical contexts for RB. To optimise therapeutic efficacy and enhance outcomes for patients with RB, combination therapy including Entospletinib and additional targeted medicines or conventional treatments ought to be investigated.
Conclusion(s)
This study reveals that SYK inhibitor Entospletinib impedes the viability of RB cells by modulating the expression levels of both proapoptotic and anti-apoptotic genes. It also targets TNF-α/NFκB gene expression, suggesting a potential mechanism for inhibiting RB cell migration. This study is the first to provide evidence that Entospletinib regulates proliferation and apoptosis in RB cells. However, it is crucial to note that clinical applications of Entospletinib require further exploration through in-vivo research to elucidate its specific anti-cancer mechanisms. Such studies may open the door to the development of innovative medications with therapeutic potential in RB.